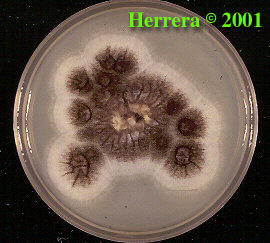

Amikor a gombákra gondolunk először azok a gombák jutnak eszünkbe, melyekkel a piacon találkozunk. Ezek termőtestes, vagy más néven bazídiumos gombák. A bazídiumos gombák nagytestű gombák, fonalaik teleptestbe rendeződnek. Kalaposgombáknak is nevezik őket, a bazídium a kalap belsejében van, a fonalak végén megvastagodott képlet, azon termelődnek a spórák. Mintegy 30 000 bazídiumos gombafaj ismert. Ide tartozik a legtöbb ehető és termesztett gomba is. Azonban léteznek kisméretű gombák is, más néven mikrogombák. Ezeknek köszönhetően kel meg a kenyér, vagy erjed meg a must, sőt még antibiotikumok termelésére is képesek. Némely faj a bőr és nyálkahártya betegségeit okozzák, vagy növényi kártevők.